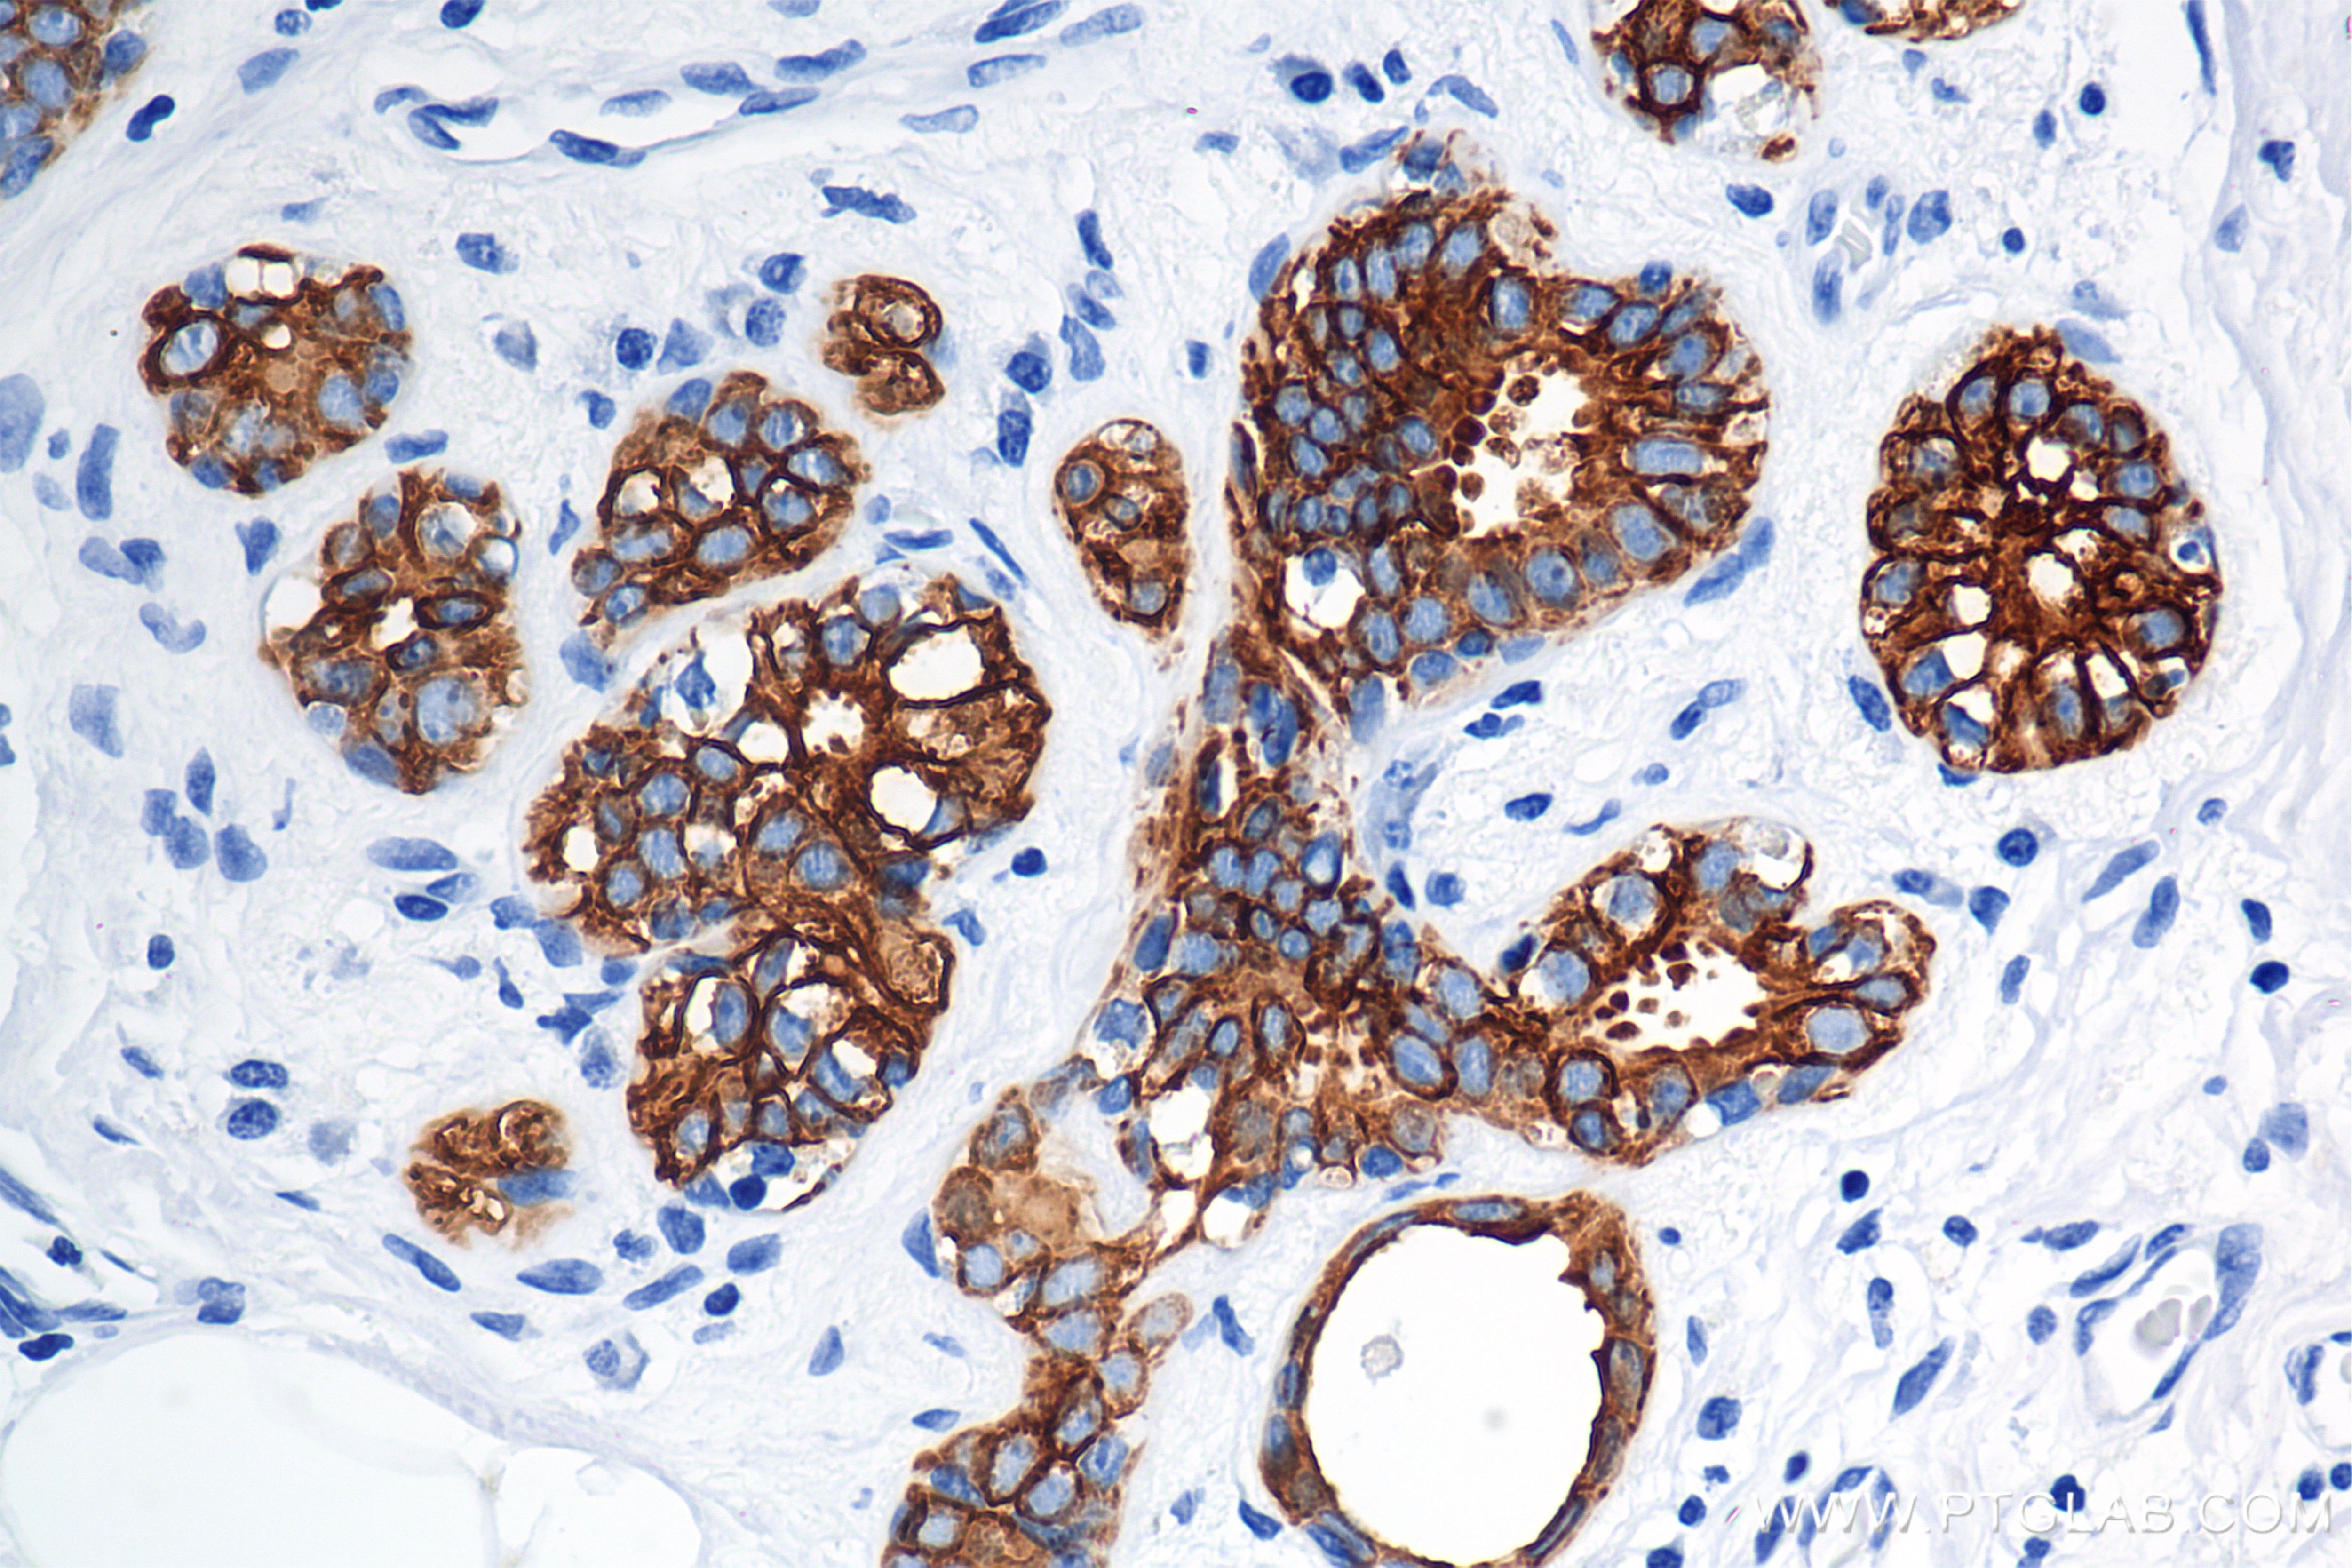
Immunohistochemistry (IHC) staining of human breast cancer tissue using Cytokeratin 7 Recombinant antibody (86153-7-RR)

Tested Applications
| Positive WB detected in | HeLa cells, A549 cells |
| Positive IHC detected in | human breast cancer tissue, human appendicitis tissue, human liver tissue, human pancreas tissue Note: suggested antigen retrieval with TE buffer pH 9.0; (*) Alternatively, antigen retrieval may be performed with citrate buffer pH 6.0 |
| Positive IF-P detected in | human breast cancer tissue |
| Positive IF/ICC detected in | HEPG2 cells |
Recommended dilution
| Application | Dilution |
|---|---|
| Western Blot (WB) | WB : 1:5000-1:50000 |
| Immunohistochemistry (IHC) | IHC : 1:1000-1:4000 |
| Immunofluorescence (IF)-P | IF-P : 1:50-1:500 |
| Immunofluorescence (IF)/ICC | IF/ICC : 1:1000-1:4000 |
| It is recommended that this reagent should be titrated in each testing system to obtain optimal results. | |
| Sample-dependent, Check data in validation data gallery. | |
Product Information
86153-7-RR targets Cytokeratin 7 in WB, IHC, IF/ICC, IF-P, ELISA applications and shows reactivity with human samples.
| Tested Reactivity | human |
| Host / Isotype | Rabbit / IgG |
| Class | Recombinant |
| Type | Antibody |
| Immunogen |
Peptide Predict reactive species |
| Full Name | keratin 7 |
| Calculated Molecular Weight | 51 kDa |
| Observed Molecular Weight | 51 kDa |
| GenBank Accession Number | NM_005556 |
| Gene Symbol | Cytokeratin 7 |
| Gene ID (NCBI) | 3855 |
| Conjugate | Unconjugated |
| Form | Liquid |
| Purification Method | Protein A purification |
| UNIPROT ID | P08729 |
| Storage Buffer | PBS with 0.02% sodium azide and 50% glycerol, pH 7.3. |
| Storage Conditions | Store at -20°C. Stable for one year after shipment. Aliquoting is unnecessary for -20oC storage. 20ul sizes contain 0.1% BSA. |
Background Information
Cytokeratin 7 (CK7) is a type II keratin protein that is a principal constituent of the intermediate filament cytoskeleton. It is primarily expressed in simple epithelia lining the cavities of internal organs, glandular ducts, and blood vessels. Abnormal expression of CK7 has been linked to various pathological conditions, including cancer. Overexpression of CK7 promotes tumor progression and metastasis in different human cancers, and its suppression leads to rapid tumor regression, highlighting its potential as a therapeutic target CK7 is also involved in inhibiting interferon-dependent interphase, promoting DNA synthesis, initiating translation possibly through interaction with p150 (the largest subunit of eukaryotic translation initiation factor 3), and interacting with G protein-coupled estrogen receptor 1 (GPER1), which activates several signaling pathways. In the context of cancer diagnosis, CK7 is used as a marker to distinguish between different types of carcinomas. It is expressed in most adenocarcinomas, particularly those of the lung and colorectal origin, and is useful in differentiating primary ovarian carcinoma from metastatic colorectal carcinoma. CK7 expression has also been studied as a predictor of an unfavorable prognosis in colorectal carcinoma.
Protocols
| Product Specific Protocols | |
|---|---|
| FC protocol for Cytokeratin 7 antibody 86153-7-RR | Download protocol |
| IF protocol for Cytokeratin 7 antibody 86153-7-RR | Download protocol |
| IHC protocol for Cytokeratin 7 antibody 86153-7-RR | Download protocol |
| WB protocol for Cytokeratin 7 antibody 86153-7-RR | Download protocol |
| Standard Protocols | |
|---|---|
| Click here to view our Standard Protocols |